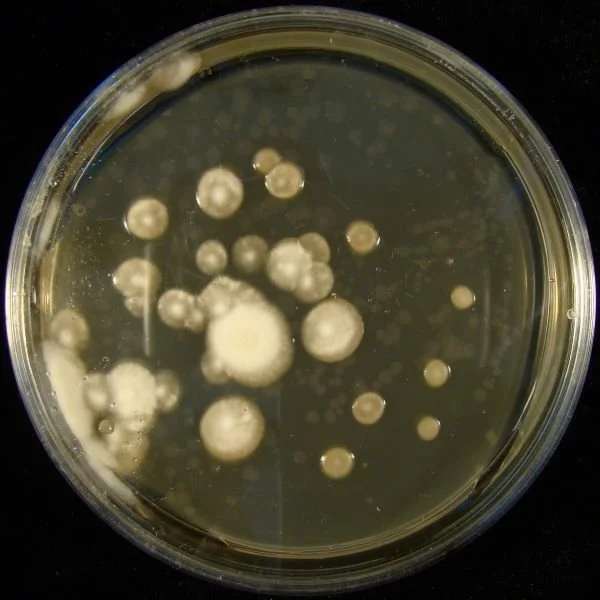
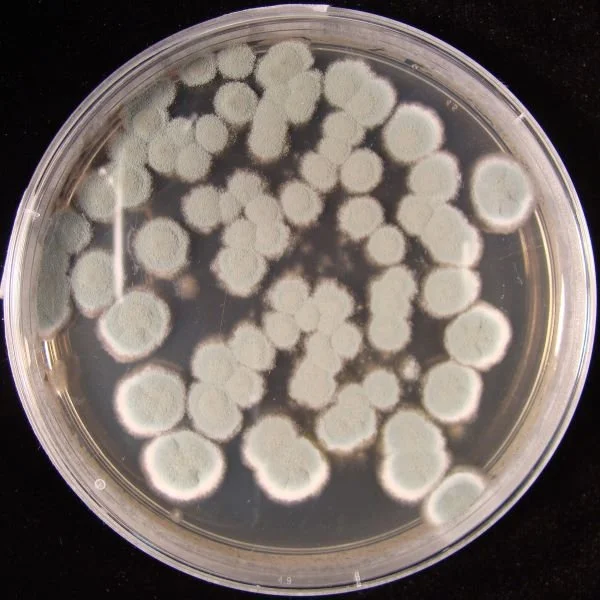
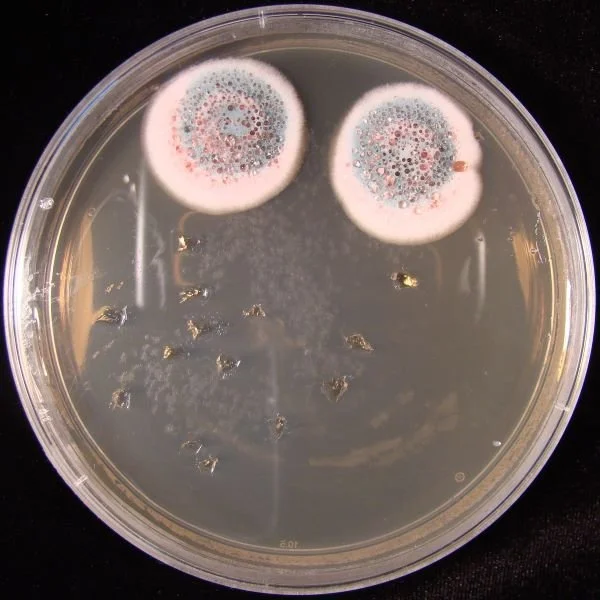
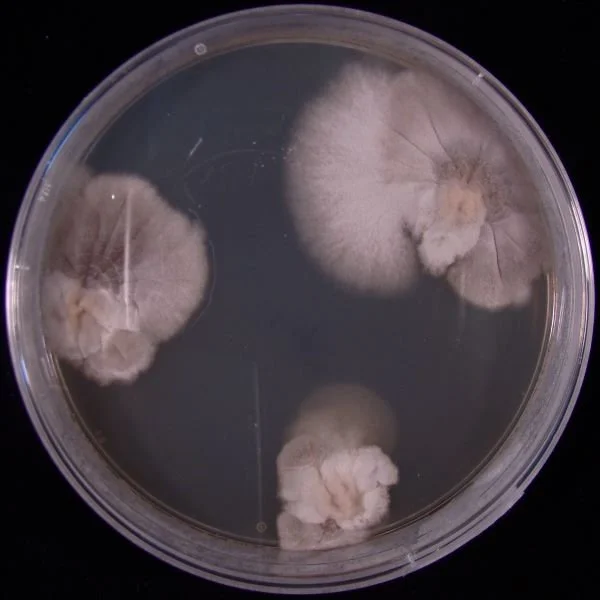

Collected Contaminants
2016 - 2018
Back when I was a lab scientist, I discovered that our cool room (large walk-in fridge) was full. Cool rooms are a close relative of the shared workplace fridge, in that they are often filled with abandoned, rotting things left by previous employees, or half-finished things that have been forgotten…
I cleaned out several shelves and photograpged the best of the contaminated plates. I’ve labelled this series as a collaboration, as these plates would have been inadvertently contaminated by many scientists over many years.